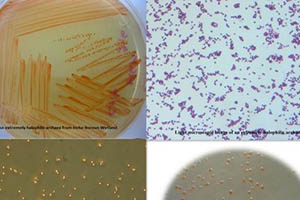

پخش زنده
امروز: -
دومین گونه باکتری از جنس Aliidiomarina از تالاب بین المللی گمیشان توسط محققان بانک میکروارگانیسمهای مرکز ملی ذخایر ژنتیکی و زیستی ایران شناسایی و معرفی شد.
به گزارش خبرگزاری صدا و سیما به نقل از روابط عمومی مرکز ملی ذخایر ژنتیکی و زیستی ایران، دکتر سید ابوالحسن شاهزاده فاضلی رئیس مرکز در خصوص این گونه باکتری گفت: تالاب گمیشان یک اکوسیستم قلیایی، شور و دریایی مهم است که در شمال غربی شهر گرگان واقع شده است.
وی افزود: محققان مرکز در راستای کشف میکروارگانیسمهای بومی مهم ایران، جامعه باکتریایی این تالاب را بررسی کردند و طی این پژوهش موفق به کشف گونه جدیدی از جنس Aliidiomarina شدند که Aliidiomarina sedimenti نامگذاری شده است.
رئیس مرکز ملی ذخایر ژنتیکی و زیستی ایران گفت: این باکتری هالو آلکالوفیل و از رده Gammaproteobacteria است که کشف آن در ژورنال معتبر بین المللی IJSEM منتشر و به جامعه علمی دنیا معرفی شده است.
این سویه هم اکنون با شماره دسترسی IBRC-M ۱۰۷۶۴ در کاتالوگ رسمی بانک میکروارگانیسم ها، برای کلیه محققان داخلی و خارجی قابل دسترسی و ارائه است.
پیش از این، از این تالاب گونهی دیگری از جنس مذکور تحت عنوان Aliidiomarina iranensis با شماره دسترسی IBRC-M ۱۰۷۶۳ توسط محققان این مرکز کشف و معرفی شده بود.